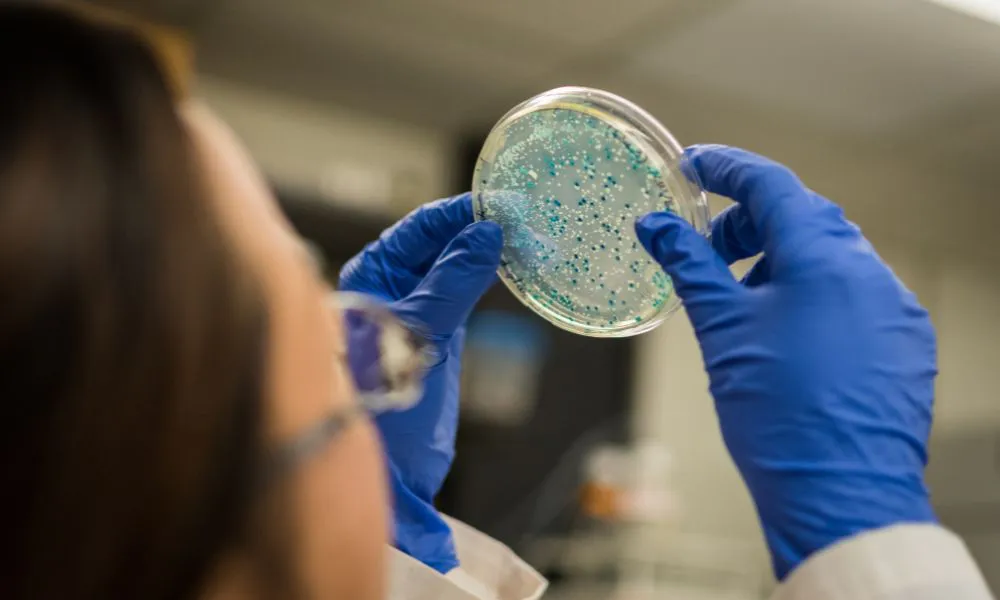
Resistencia antimicrobiana

medicina

UN INNOVADOR IMPLANTE DE RETINA PODRÍA DEVOLVER LA VISTA A PACIENTES
Científicos en Francia trabajan en un dispositivo revolucionario que busca reparar el tejido ocular dañado y permitir que las personas con pérdida de visión puedan volver a ver.

Investigadores españoles lograron aplicar un tratamiento innovador para mejorar la movilidad de pacientes con Parkinson. La técnica utiliza ultrasonidos de alta intensidad y evita la cirugía.

Las empresas de medicina prepaga anunciaron que realiarán nuevos aumentos en noviembre, superando la inflación mensual, afectando a sus afiliados.

El Dr. Alejandro Crugley, dialogó con #LA17 sobre la importancia de los controles en niños. Este 15 de octubre se recuerda el Día Mundial de la Ambliopía.

Los biólogos Victor Ambros y Gary Ruvkun recibieron el Nobel de Medicina por su descubrimiento del microRNA, una revolución en la regulación genética.

La Superintendencia de Servicios de Salud anunció una nueva resolución. Desde diciembre, las prepagas recibirán aportes directos, sin pasar por obras sociales.


